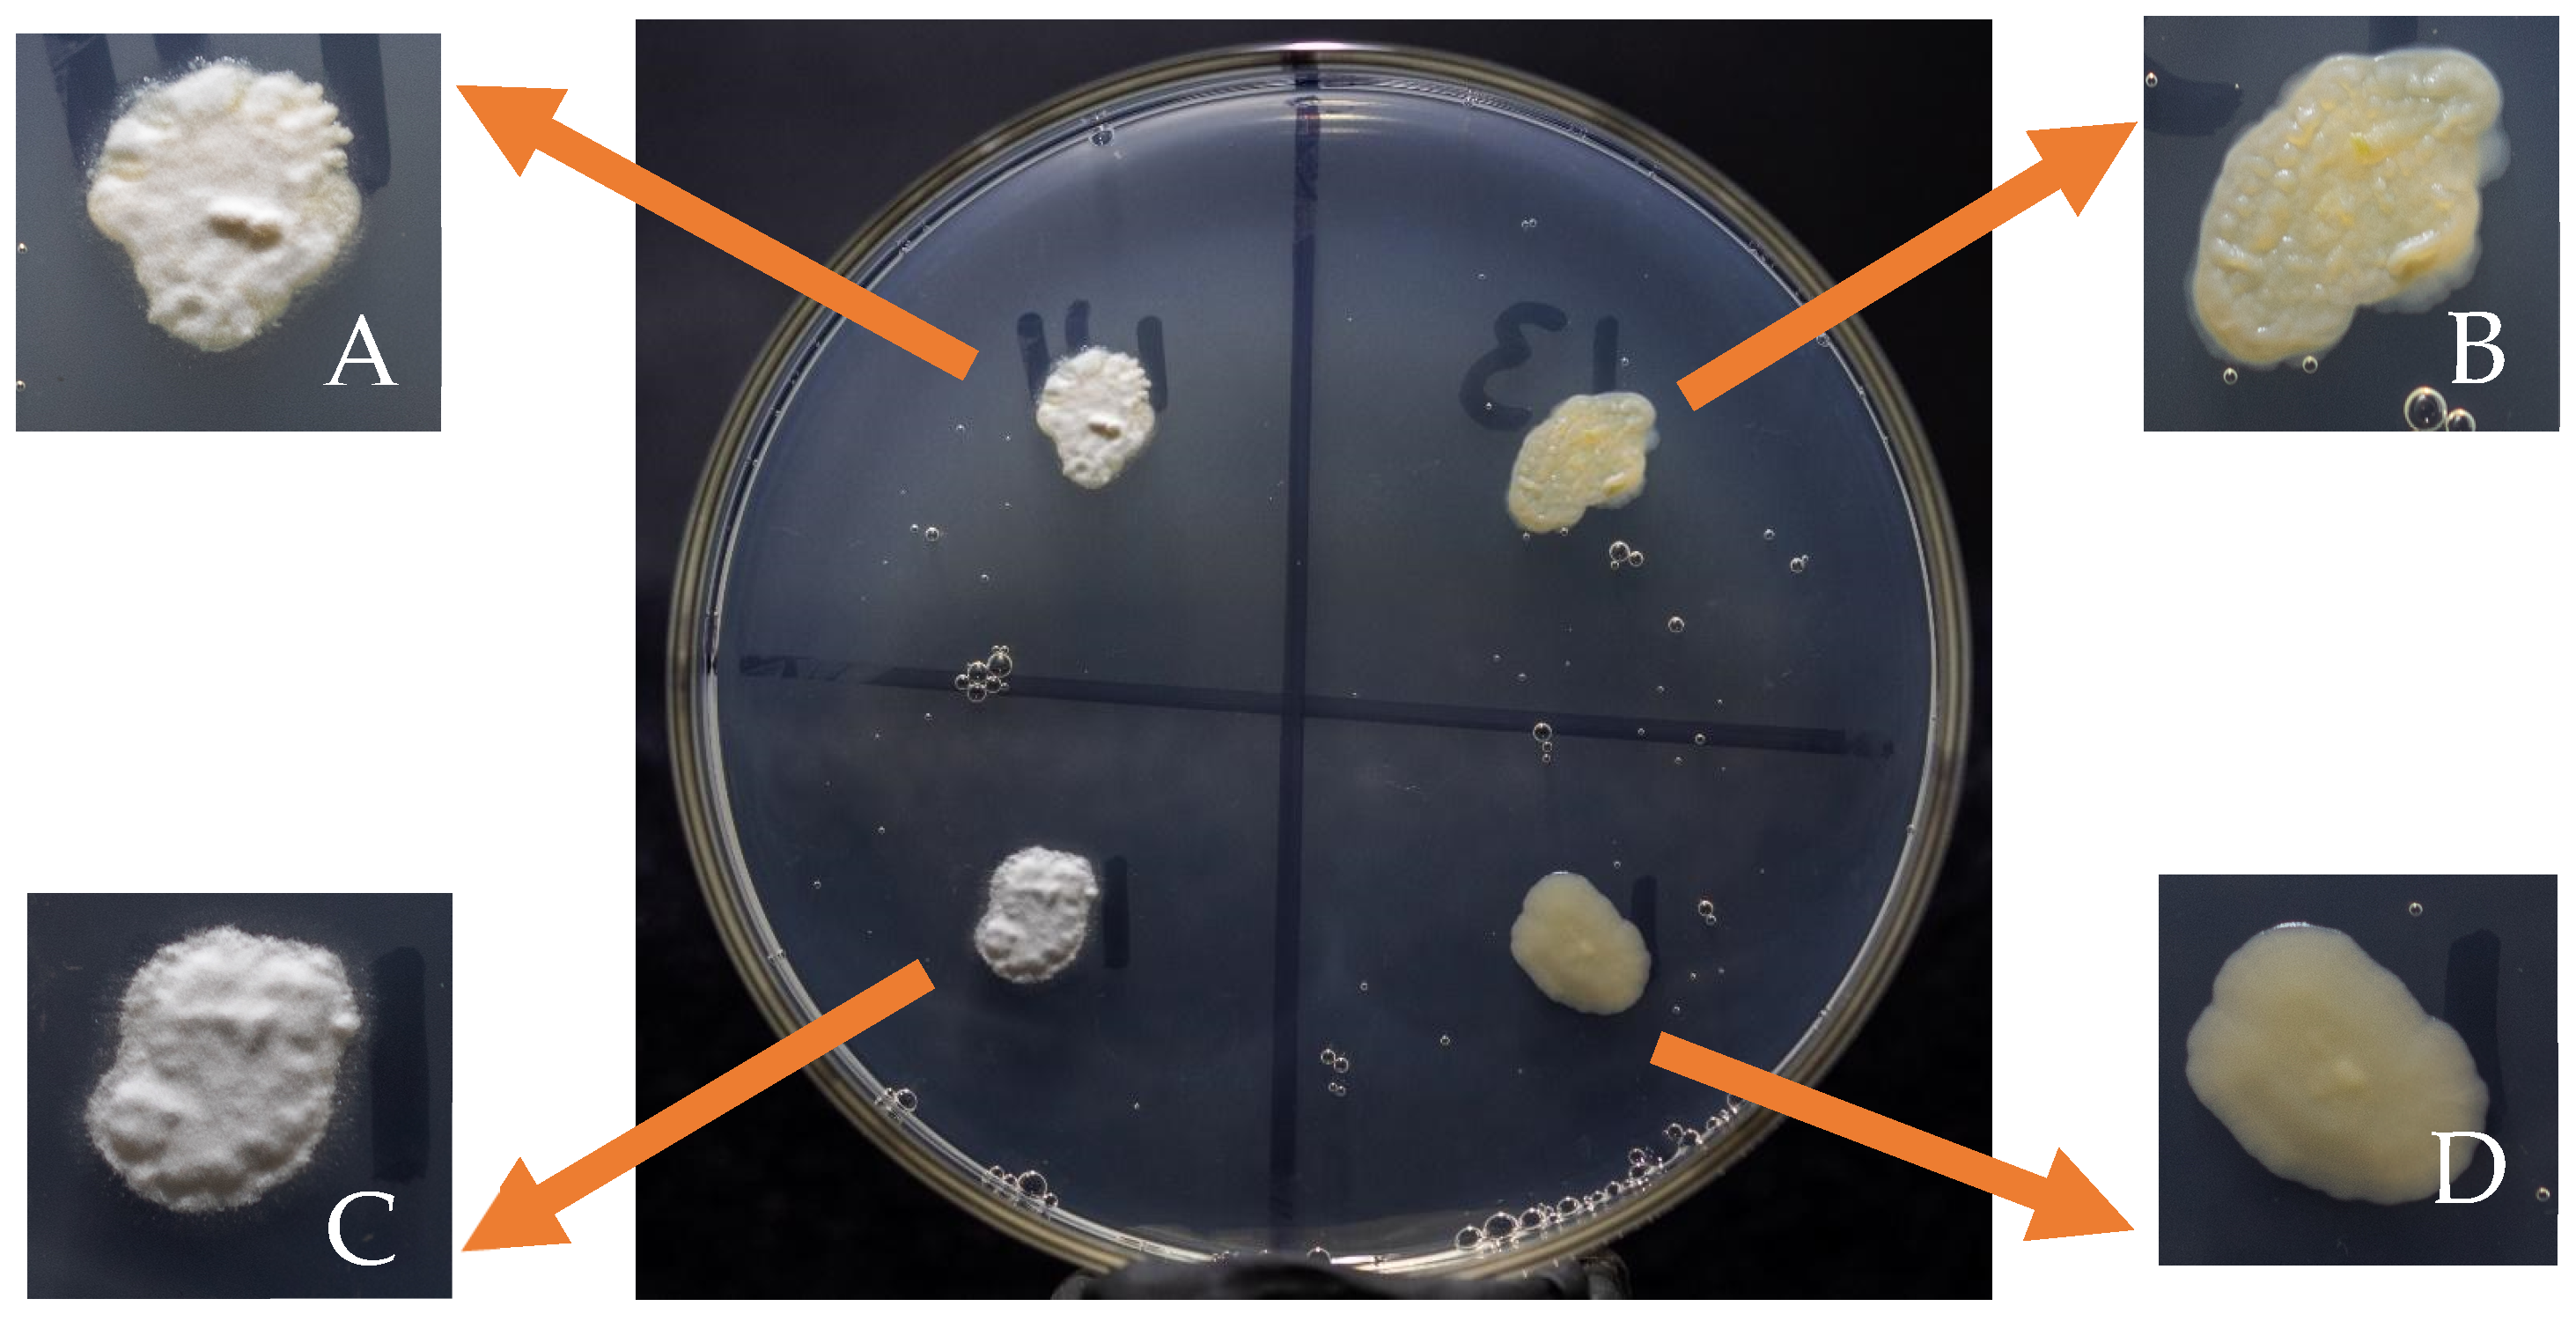

A New Method to Obtain Infective Ustilago maydis Binucleate Conidia for Corn Smut Production
Abstract
1. Introduction
2. Material and Methods
2.1. Biological Material
2.2. Isolation of Haploid Sporidia and Dikaryotic Conidia
2.3. Morphological Characterization of Haploid Strains and Dikaryotic Conidia
2.4. U. maydis Inoculation in Corn Plants
2.5. Analysis of Severity Degree, Infection Rate, Yield, and Production
2.6. Data Analysis
3. Results
3.1. Isolation of Haploid and Dikaryotic Sporidia
3.2. Preliminary Analysis of Strains from Mature or Immature Galls in Corn Crops
3.3. Evaluation of 23 U. maydis Dikaryotic Strains Capable of Producing Galls in Baby Corn Ears
4. Discussion
5. Conclusions
Author Contributions
Funding
Data Availability Statement
Conflicts of Interest
References
- Bölker, M.; Urban, M.; Kahmann, R. The mating type locus of U. maydis specifies cell signaling components. Cell 1992, 68, 441–450. [Google Scholar] [CrossRef] [PubMed]
- Banuett, F. Ustilago maydis, the delightful blight. Trends Genet. 1992, 8, 174–180. [Google Scholar] [CrossRef] [PubMed]
- Banuett, F. Genetics of Ustilago maydis, a fungal pathogen that induces tumors in maize. Annu. Rev. Genet. 1995, 29, 179–208. [Google Scholar] [CrossRef] [PubMed]
- Kronstad, J.W. Castles and cuitlacoche: The first international Ustilago conference. Fungal Genet. Biol. 2003, 38, 265–271. [Google Scholar] [CrossRef] [PubMed]
- Banuett, F.; Herskowitz, I. Different alleles of Ustilago maydis are necessary for maintenance of filamentous growth but not for meiosis. Proc. Natl. Acad. Sci. USA 1989, 86, 5878–5882. [Google Scholar] [CrossRef] [PubMed]
- Martínez, L.; Villanueva, C.; Sahagún, J. Susceptibilidad y resistencia del maíz al hongo comestible huitlacoche (Ustilago maydis Cda.) mejorando su virulencia. Rev. Chapingo Ser. Hortic. 2000, 6, 241–248. [Google Scholar] [CrossRef]
- Madrigal-Rodríguez, J.; Villanueva-Verduzco, C.; Sahagún-Castellanos, J.; Acosta Ramos, M.; Martínez Martínez, L.; Espinosa Solares, T. Ensayos de producción de huitlacoche (Ustilago maydis Cda.) hidropónico en invernadero. Rev. Chapingo Ser. Hortic. 2010, 16, 177–182. [Google Scholar] [CrossRef]
- Pataky, J.K. Production of cuitlacoche [Ustilago maydis (DS) Corda] on sweet corn. HortScience 1991, 26, 1374–1377. [Google Scholar] [CrossRef]
- Valverde, M.E.; Paredes-López, O.; Pataky, J.K.; Guevara-Lara, F.; Pineda, T.S. Huitlacoche (Ustilago maydis) as a food source—Biology, composition, and production. Crit. Rev. Food Sci. Nutr. 1995, 35, 191–229. [Google Scholar] [CrossRef] [PubMed]
- Pan, J.; Baumgarten, M.; May, G. Effects of host plant enviroment and Ustilago maydis infection of the fungal endophyte community of maize (Zea mays). New Phytol. 2008, 178, 147–156. [Google Scholar] [CrossRef] [PubMed]
- Valdez, M.M.; Valverde, M.E.; Paredes, L.O. Procedimiento Tecnológico para la Producción Masiva de Huitlacoche; CINVESTAV-Irapuato: Irapuato, Mexico, 2009; pp. 10–37. [Google Scholar]
- Salazar, T.J.C.; Martínez, T.E.; Álvarez, H.R.; Méndez, L.A. Susceptibilidad de maíces híbridos y criollos al huitlacoche (Ustilago maydis (DC) CDA.), y rentabilidad de la producción. In Chapingo, México. Ciencias Agronómicas y Ambientales. 1er Congreso Internacional de Ciencias Aplicadas; Universidad Autónoma de Chapingo: Texcoco, Mexico, 2013; pp. 84–93. [Google Scholar]
- Aguayo-González, D.J.; Acosta-Ramos, M.; Pérez-Cabrera, L.E.; Guevara-Lara, F.; García Munguía, A.M. Producción natural de huitlacoche [Ustilago maydis (DC) Corda] en el estado de Aguascalientes. Rev. Mex. Cienc. Agríc. 2016, 7, 1043–1050. [Google Scholar] [CrossRef][Green Version]
- Pataky, J.K.; Chandler, M.A. Production of huitlacoche, Ustilago maydis: Timing inoculation and controlling pollination. Mycologia 2003, 95, 1261–1270. [Google Scholar] [CrossRef] [PubMed]
- Garcilazo Rahme, O.; Tello Salgado, I.; Mata, G.; Parraguirre Lezama, C.; de Ita, M.D.L.A.V.; Romero Arenas, O. Evaluation of Eight Genotypes of Corn for the Commercial Cultivation of Huitlacoche in Nopalucan, Puebla, Mexico. Agriculture 2020, 10, 535. [Google Scholar] [CrossRef]
- Calderón, F. Caracterización Clásica y Molecular del Ustilago maydis D.C. (Corda), Hongo de Importancia Social y Económica en la Región Central de México. Ph.D. Thesis, Colegio de Postgraduados en Ciencias Agrícolas, Texcoco, Mexico, 2010. [Google Scholar]
- Strom, N.B.; Bushley, K.E. Two genomes are better than one: History, genetics, and biotechnological applications of fungal heterokaryons. Fungal Biol. Biotechnol. 2016, 3, 4. [Google Scholar] [CrossRef]

| Gall Appearance | ISE | SEVi (UM-UAEM) | ||||
|---|---|---|---|---|---|---|
| G0 | G1 | G2 | G3 | G4 | ||
| Small–white | 25 | 7 | ||||
| Small–grey | 25 | 17 | ||||
| Large–white | 25 | |||||
| Large–grey | 25 | 57 | 64, 65, 69, 72, 73, 75, 99 | |||
| Small–spotted | 25 | |||||
| Small–white | 50 | |||||
| Small–grey | 50 | 169 | 2, 58 | 198 | 50, 160 | |
| Large–white | 50 | 86, 187 | ||||
| Large–grey | 50 | 5, 21, 51, 62, 67, 83, 114, 132, 155, 170, 175 | ||||
| Small–spotted | 50 | 19 | ||||
| Large–spotted | 50 | 186 | ||||
| Small–white | 75 | 80 | 40 | 41 | ||
| Small–grey | 75 | 47 | 25, 26, 35, 74 | 1, 4, 31, 39, 61, 68, 70 | ||
| Large–white | 75 | |||||
| Large–grey | 75 | 36, 43, 45, 48, 95 | 28, 30, 37, 42, 89 | 6, 91, 94, 100 | ||
| Small–spotted | 75 | 14, 18, 23, 76, 77 | ||||
| Small–white | 100 | 3 | 10, 34, 46,134,135,161 | |||
| Small–grey | 100 | 27 | 53, 201 | 13, 20, 199 | 8, 11, 12, 15, 28, 55, 59, 79, 81, 90, 93, 102, 158, 163, 200 | |
| Large–white | 100 | 133 | ||||
| Large–grey | 100 | 96, 202 | 104, 110, 111, 151 | 29, 33, 78, 92, 105, 106, 108, 109, 112, 113, 117, 119, 120, 123, 124, 126, 128, 130, 131, 137, 138, 139, 142, 147, 152, 156, 159, 162, 167, 176, 177, 182, 183, 184, 185, 191 | ||
| Small–spotted | 100 | 38 | 32, 103, 116 | 22, 84, 85, 165 | ||
| Large–spotted | 100 | 118, 141 | ||||
| Strains Inoculated | Baby Corn Ears Infected | Infection Count | Infection Rate | Severity Degree |
|---|---|---|---|---|
| 206 | 824 | 71.35% | 71.3% | G4 |
| Selected Strains | Average Gall Weight (g) | Infection Rate (%) | Severity Degree | Yield per Plant Inoculated (th−1) | Yield per Hectare, RPH (th−1) |
|---|---|---|---|---|---|
| Um-UAEMor-6 | 119.73 ± 44.11 HFGE | 100 | G4 | 5.98 ± 2.32 | 7.18 |
| Um-UAEMor-8 | 137.18 ± 59.21 DFE | 100 | G4 | 8.06 ± 3.71 | 8.23 |
| Um-UAEMor-11 | 151.07 ± 54.18 DCE | 100 | G4 | 10.79 ± 4.01 | 9.06 |
| Um-UAEMor-23 | 157.5 ± 40.04 DCE | 100 | G4 | 9.84 ± 2.50 | 9.45 |
| Um-UAEMor-24 | 125.78 ± 37.00 DFGE | 100 | G4 | 6.62 ± 1.93 | 7.54 |
| Um-UAEMor-28 | 145 ± 70.54 DFCE | 100 | G4 | 9.06 ± 4.40 | 8.70 |
| Um-UAEMor-31 | 156.5 ± 40.33 DCE | 100 | G4 | 7.82 ± 2.05 | 9.39 |
| Um-UAEMor-34 | 145.29 ± 56.65 DFCE | 100 | G4 | 8.07 ± 3.72 | 8.71 |
| Um-UAEMor-39 | 175.55 ± 75.03 DC | 100 | G4 | 9.75 ± 3.94 | 10.53 |
| Um-UAEMor-59 | 153.52 ± 49.31 DCE | 100 | G4 | 9.03 ± 2.86 | 9.21 |
| Um-UAEMor-61 | 78.46 ± 34.32 HGI | 100 | G4 | 6.03 ± 2.74 | 4.70 |
| Um-UAEMor-68 | 73.57 ± 30.02 HI | 100 | G4 | 5.25 ± 2.14 | 4.41 |
| Um-UAEMor-78 * | 360.83 ± 107.49 A | 100 | G4 | 20.04 ± 4.71 * | 21.65 |
| Um-UAEMor-79 | 85.78 ± 50.00 HGI | 100 | G4 | 4.28 ± 2.58 | 5.14 |
| Um-UAEMor-91 | 75.16 ± 35.46 HGI | 75 | G3 | 3.75 ± 1.93 | 4.51 |
| Um-UAEMor-92 | 100 ± 20.25 HFGI | 100 | G4 | 7.14 ± 2.30 | 4.20 |
| Um-UAEMor-93 | 189.73 ± 72.66 C | 100 | G4 | 9.98 ± 3.52 | 11.38 |
| Um-UAEMor-94 | 73.57 ± 46.15 I | 100 | G4 | 5.25 ± 2.41 | 4.41 |
| Um-UAEMor-120 * | 371.86 ± 119.03 A | 100 | G4 | 18.59 ± 2.09 * | 22.31 |
| Um-UAEMor-138 | 121.25 ± 69.02 HFGE | 100 | G4 | 6.06 ± 3.10 | 7.27 |
| Um-UAEMor-155 | 85.78 ± 50.28 HGI | 100 | G4 | 4.51 ± 2.67 | 5.14 |
| Um-UAEMor-185 | 85 ± 57.17 HGI | 100 | G4 | 5.00 ± 3.27 | 5.10 |
| Um-UAEMor-187 * | 383.25 ± 137.17 A | 100 | G4 | 19.16 ± 6.49 * | 22.99 |
| CP-436 X CP-437 | 296.75 ± 107.49 B | 100 | G4 | 14.83 ± 3.57 * | 17.80 |
Disclaimer/Publisher’s Note: The statements, opinions and data contained in all publications are solely those of the individual author(s) and contributor(s) and not of MDPI and/or the editor(s). MDPI and/or the editor(s) disclaim responsibility for any injury to people or property resulting from any ideas, methods, instructions or products referred to in the content. |
© 2024 by the authors. Licensee MDPI, Basel, Switzerland. This article is an open access article distributed under the terms and conditions of the Creative Commons Attribution (CC BY) license (https://creativecommons.org/licenses/by/4.0/).
Share and Cite
Tello-Salgado, I.; Hernández-Castañeda, D.T.; Montiel-Arcos, E.; Nava-García, E.; Martínez-Carrera, D. A New Method to Obtain Infective Ustilago maydis Binucleate Conidia for Corn Smut Production. Agriculture 2024, 14, 672. https://doi.org/10.3390/agriculture14050672
Tello-Salgado I, Hernández-Castañeda DT, Montiel-Arcos E, Nava-García E, Martínez-Carrera D. A New Method to Obtain Infective Ustilago maydis Binucleate Conidia for Corn Smut Production. Agriculture. 2024; 14(5):672. https://doi.org/10.3390/agriculture14050672
Chicago/Turabian StyleTello-Salgado, Isaac, Dulce Teresa Hernández-Castañeda, Elizur Montiel-Arcos, Elizabeth Nava-García, and Daniel Martínez-Carrera. 2024. "A New Method to Obtain Infective Ustilago maydis Binucleate Conidia for Corn Smut Production" Agriculture 14, no. 5: 672. https://doi.org/10.3390/agriculture14050672
APA StyleTello-Salgado, I., Hernández-Castañeda, D. T., Montiel-Arcos, E., Nava-García, E., & Martínez-Carrera, D. (2024). A New Method to Obtain Infective Ustilago maydis Binucleate Conidia for Corn Smut Production. Agriculture, 14(5), 672. https://doi.org/10.3390/agriculture14050672

